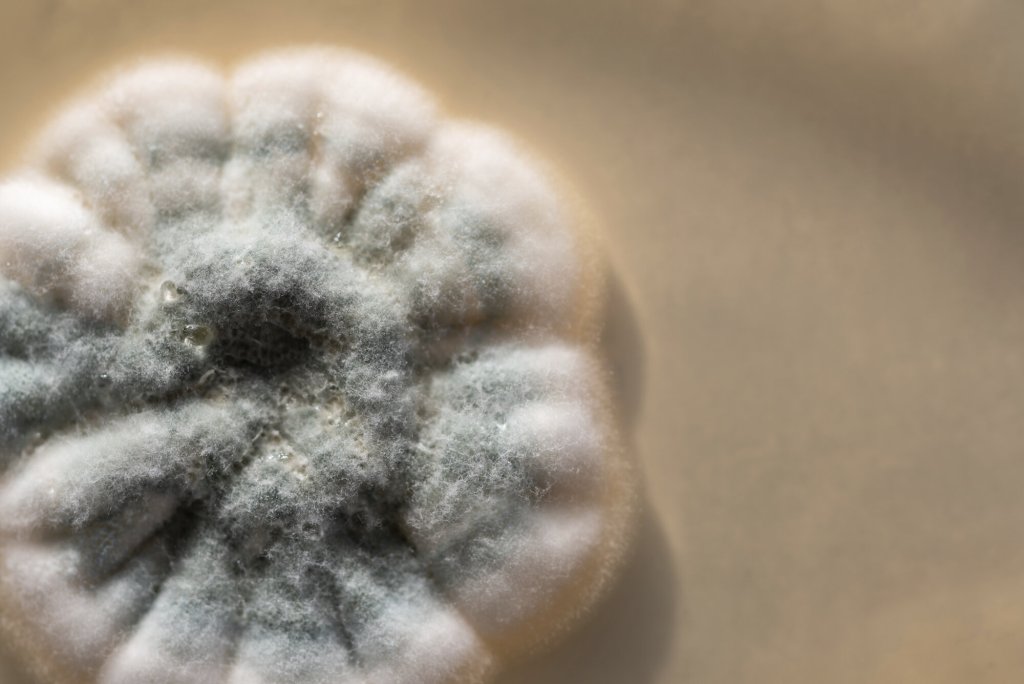
Penicillin Bildet viser penicillin som vokser på medium i en petriskål.

– For mange har cave penicillin i journalen

Å være oppført med penicillinallergi gjør at andre typer antibiotika må brukes. Det kan føre til dårligere behandling for pasienten og mer resistens i samfunnet.
En av ti pasienter innlagt på sykehus har ifølge studier cave penicillin i journalen. Det betyr at de ikke skal ha penicillin, fordi de tidligere har reagert på medikamentet.
– Men når man utreder disse pasientene, viser det seg at svært mange ikke er allergiske, forteller Ingvild Gaare-Olstad, sykepleier ved Regionalt senter for astma, allergi og overfølsomhet ved Oslo universitetssykehus.
– Diagnosen er ofte satt på feil grunnlag.
Får ikke beste behandling
Det får konsekvenser både for den enkelte pasienten, og for samfunnet.
– For pasientene kan det medføre at de ikke får førstevalget i den behandlingen de skal ha, påpeker hun.
Penicillin er en bærebjelke i all infeksjonsbehandling i Norge, enten alene eller i kombinasjon med andre typer antibiotika. Dersom det står cave penicillin i journalen, vil det bli valgt et annet alternativ, som kan være mer toksisk og gi flere bivirkninger. Det kan også bety at en kur som kunne vært gitt som tabletter, må gis intravenøst på sykehus.
Dette er med på å drive resistensutviklingen, fordi smalspektret penicillin kanskje må byttes ut mot et bredspektret antibiotikum.
Bredspektrede antibiotika virker mot flere bakterier, men påvirker i større grad tarmens normalflora og gir gode vekstvilkår for resistente bakterier.
Derfor er det i økende grad blitt oppmerksomhet på at cave penicillin ofte settes på feil grunnlag, ikke bare i allergologiske, men også i infeksjonsmedisinske miljøer.
– Må forholde seg til det
– Men det er ikke sånn at man ikke skal ta hensyn til cave penicillin i journalen, understreker Ingvild Gaare-Olstad.
– Anafylaksi på legemidler skjer, og kan være alvorlig. Det er viktig at vi ikke får situasjoner hvor vi tenker «Det er så få som egentlig har penicillinallergi», og behandler pasienten med noe som potensielt kan få en fatal utgang.
Generelt er alvorlige allergiske reaksjoner på medikamenter sjeldne.
– Men penicillinallergi er blant de vanligste formene for medikamentallergi, påpeker hun.
En allergi mot penicillin kan fremkalle anafylaksi, en potensielt livstruende systemisk overfølsomhetsreaksjon, som i verste fall fører til død.
– Står det cave penicillin, må man forholde seg til det, sier hun.
– Men det er for mange som har det i journalen.

– Vanskelig å ta bort
På avdelingen der hun jobber, er utredning for penicillinallergi noe som gjøres ukentlig. Ventelistene er lange, og utredningen omfattende.
– Vi må være veldig sikre før vi kan avkrefte en allergi. Å ta bort cave fra journalen er vanskelig, sier hun.
– Derfor ønsker vi mer oppmerksomhet på at det må være godt grunnlag for å sette denne diagnosen.
75 prosent av dem som har cave penicillin i journalen, har fått diagnosen innen de fylte tre år, ofte i forbindelse med at de er behandlet for infeksjoner. Når de blir henvist til utredning for penicillinallergi som 70-åringer, kan det være vanskelig å finne ut av om de hadde en reell allergisk reaksjon på penicillinet da de var barn.
– Mange forteller at de reagerte på penicillin med utslett, forteller Gaare-Olstad.
– Det kan være en reaksjon på legemiddelet, samtidig er det også vanlig med utslett ved infeksjoner. Hvis reaksjonen eller utslettet ikke ble undersøkt ordentlig, kan det ha blitt oppfattet som allergi, selv om det ikke var det.
Også bivirkninger, som for eksempel diare og kvalme, kan feiltolkes som allergiske reaksjoner.
De fleste har det ikke
– Et viktig prinsipp for allergiutvikling er at eksponering fører til en immunologisk respons, som kan gi allergisk reaksjon ved reeksponering, forklarer Ingvild Gaare-Olstad.
– Det viktigste i utredningen er å starte med en grundig gjennomgang av sykehistorien, hvor vi går gjennom hva som er gitt, tidsrelasjon til reaksjonen og beskrivelse av reaksjonen.
De allergiske reaksjonene på legemidler kommer enten raskt etter eksponering, ofte innen en time, eller de kan komme som en senreaksjon etter flere timer eller dager med behandling. Tidsrelasjonen kan styrke eller svekke mistanken om at det var en allergisk reaksjon, og kan gi signaler om hvilke mekanismer som ligger bak. Det vil igjen legge føringer for videre utredning.
– I tillegg til den allergologiske anamnesen benytter vi ofte blodprøver, hudtester og eventuelt provokasjon i utredningen, forteller hun.
Provokasjon innebærer at pasienten får graderte doser av penicillin på sykehus, under observasjon og med beredskap for å håndtere eventuelle reaksjoner.
– De aller fleste som går gjennom utredning for penicillinallergi hos oss, er ikke allergiske, sier hun.
– Jeg kan ikke si om tallene stemmer overens med internasjonale studier, men erfaringen er at de fleste som tror de ikke tåler penicillin, kan få det. Men det krever at de utredes.

Ingen nasjonal retningslinje
Oddvar Oppegaard, overlege ved infeksjonsseksjonen på Haukeland universitetssjukehus, peker på at det ikke finnes noen nasjonal retningslinje for å sortere ut dem med reell allergi.
– Og det varierer nok litt hva man gjør for å komme til bunns i om det er allergi eller ikke, sier han.
På Haukeland prøver infeksjonsseksjonen ut et verktøy for å sortere ut dem som ikke er allergiske. Det skjer i samarbeid med seksjon for klinisk spesialallergologi.
Utprøvingen startet i mars 2021, og verktøyet er laget med utgangspunkt i danske retningslinjer.
Ut fra anamnesen deles pasientene inn i tre grupper:
- De der sykehistorien gjør det åpenbart at det ikke dreide seg om en allergisk reaksjon. Et eksempel på det kan være at de har fått et penicillinpreparat etter at cave penicillin er satt, og tålt det fint.
- De der sykehistorien viser at de har hatt en alvorlig reaksjon på penicillin. De henvises til videre utredning, etter behandling.
- De som har hatt diffuse symptomer, for eksempel hatt litt utslett. De blir provokasjonstestet mens de er innlagt på infeksjonsposten.
I snitt en i uken
Som infeksjonslege er cave penicillin noe Oddvar Oppegaard jevnlig støter på.
– I snitt har vi en pasient i uken som har cave penicillin i journalen, sier han.
Ved å sortere ut dem uten reell allergi, kan flere få den behandlingen som er best.
– Og vi bruker mindre resistensdrivende medikamenter. Det er viktig på et overordnet nivå.
Ta quiz: Hva vet du om penicillin?

0 Kommentarer